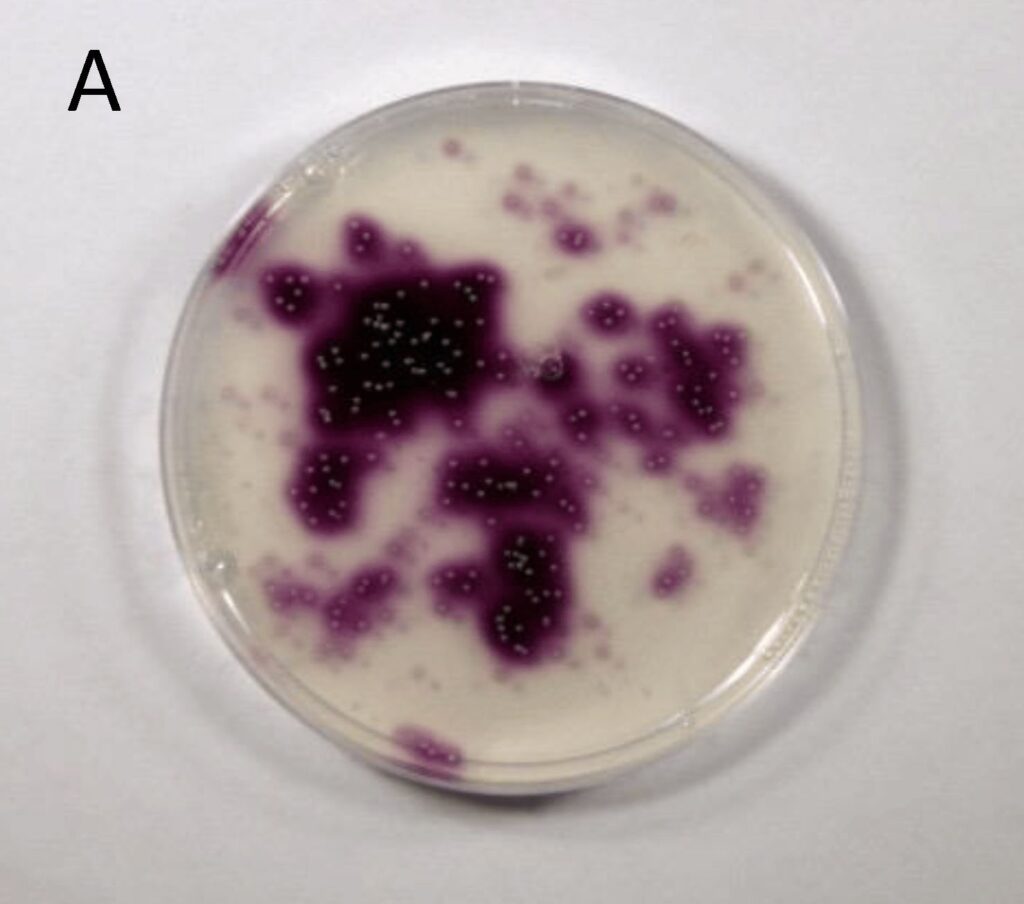

For millennia, humanity has gazed upon the cosmos, pondering our place within its vastness and the eventual fate of our vibrant blue planet. While stories of apocalyptic events often fuel our imaginations, the true narrative of Earth’s end is far more profound, rooted in the inexorable laws of stellar evolution and planetary dynamics. Recent groundbreaking research, a powerful collaboration between scientists from Toho University in Japan and NASA, has utilized advanced supercomputer simulations to peer into this distant future, offering a timeline that is both startlingly precise and considerably sooner than many once believed.
These clever people are now saying that the apocalypse may come far sooner than they thought, moving beyond speculative tales to present a meticulously modeled future. Through an astonishing 400,000 computer simulations, these researchers have crafted a comprehensive vision of Earth’s atmospheric and environmental evolution, revealing not a sudden catastrophic event, but a slow, irreversible decline. This in-depth article will navigate these complex predictions, providing a thorough understanding of the scientific processes at play and their implications for every form of life, from the smallest microbe to humanity itself.
The findings challenge long-held assumptions about our planet’s lifespan and underscore the delicate balance that sustains life on Earth. We embark on a journey through geological timescales, examining the Sun’s ultimate role, the projected year when Earth becomes utterly unlivable, and the critical environmental shifts—from oxygen depletion to extreme temperatures—that will precede this ultimate demise. Prepare to explore the science behind what was once considered science fiction, gaining a profound perspective on the dynamic nature of our world.

1. **The Scientific Consensus and Supercomputer Power**The foundation of these predictions lies in a monumental scientific undertaking, bringing together the expertise of scientists from Toho University in Japan and researchers affiliated with NASA. This collaboration exemplifies the cutting edge of planetary science, leveraging some of the world’s most powerful supercomputers to model the far future of Earth’s habitability with unprecedented detail and accuracy. Their work moves beyond theoretical conjectures, grounding its conclusions in robust computational evidence.
To achieve this profound insight, the research team employed a sophisticated methodology: running 400,000 individual simulations. This extensive computational effort was not merely about brute force; it involved complex calculations based on mathematical modeling, utilizing a combined biogeochemistry and climate model. This approach allowed the scientists to explore the likely evolution of Earth’s atmosphere and climate system under a vast array of potential future scenarios, providing a comprehensive and reliable projection of planetary conditions over geological timescales.
The study, aptly titled “The future lifespan of Earth’s oxygenated atmosphere,” and published in the esteemed journal Nature Geoscience, represents a significant advancement in our understanding of planetary habitability. It provides detailed explanations and background information to give readers a thorough understanding of these complex predictions. By emphasizing factual accuracy and relying on expert sources, the authoritative tone of this research builds confidence in the presented information, educating the reader about scientific processes and their broader context.

2. **The Sun’s Inevitable Transformation**At the heart of Earth’s ultimate destiny lies the natural, yet profound, evolution of our own star, the Sun. For billions of years, the Sun has been the stable, life-giving engine of our solar system, providing the energy necessary for photosynthesis and regulating Earth’s climate. However, according to the study, the Sun will be the ultimate cause of the end of life on Earth, not through a sudden cataclysm, but through its slow, relentless transformation.
Over billions of years, the Sun will continue its life cycle, which includes a gradual expansion and an increase in its heat and luminosity. As it ages, it will become hotter and brighter, emitting more heat and profoundly affecting Earth’s climate. This process, an inherent component of stellar evolution, will slowly transform Earth into an increasingly hostile environment, moving it beyond the threshold of life as we know it.
This increase in solar output, known as solar luminosity, will gradually raise Earth’s global temperature. While the Sun currently supports life, its added heat will ultimately overcome the planet’s capacity to maintain conditions suitable for life. This isn’t a sudden burst of energy, but a steady, inexorable rise, unfolding over hundreds of millions of years, setting off a chain of environmental consequences that will reshape our world.
Read more about: The Mind-Blowing Science of Stars: Uncovering the Cosmic Truths Behind the Twinkle

3. **The Billion-Year Countdown: A New Timeline for All Life**One of the most striking conclusions from the supercomputer simulations is the precise, albeit distant, timeline for the absolute end of life on Earth. Researchers predict that our planet will become unlivable in the year 1,000,002,021. This date, approximately one billion years from now, marks the point when conditions on Earth will have become so extreme that even the most resilient microorganisms will not be able to survive.
By this distant future, the planet’s surface will be transformed beyond recognition. The models predict a scenario where the oceans will have completely evaporated, eliminating the vast majority of aquatic life and drastically altering global weather patterns. The atmosphere, once a protective blanket, will have thinned considerably, offering little defense against the Sun’s intensified radiation.
Surface temperatures will soar to levels that make life utterly impossible, even for extremophiles that thrive in today’s harshest environments. Earth, once a vibrant blue orb teeming with biodiversity, will resemble a barren, scorched wasteland. This predicted end, while billions of years away, underscores that life is by no means an indefinite feature of our planet and highlights the long-term, irreversible nature of Earth’s eventual loss of habitability.
4. **The Earlier Exit for Humanity**While the ultimate demise of even microbial life is set for a billion years hence, a more somber prediction looms for complex organisms, including humanity: our time on Earth is expected to end much, much sooner. The supercomputer models predict that human life could end far earlier than the total cessation of all life, as the Sun’s intensifying radiation triggers severe atmospheric and environmental changes that will precede the planet’s final scorching.
Rising temperatures, declining oxygen levels, and deteriorating air quality will progressively render the planet less hospitable, creating a series of compounding challenges for human survival. These effects, modeled using detailed simulations of climate change and solar radiation, suggest that the window for human habitability won’t be as long as the broader timeline for all life. This is a crucial distinction, highlighting our species’ vulnerability to even more subtle environmental shifts.
Kazumi Ozaki, the study’s lead author, noted that previous estimates suggested Earth’s biosphere would end in two billion years due to overheating and CO₂ scarcity. However, this new research narrows that timeframe, predicting rapid deoxygenation and an increasingly hostile environment for oxygen-dependent life within approximately one billion years, effectively cutting previous estimates in half. The biosphere, including humanity, could collapse long before the planet becomes a scorched wasteland.
Read more about: 15 Ingenious Victorian Life Hacks That Still Hold Up in Our Modern World

5. **The Fading Breath: Earth’s Oxygen Depletion**One of the most significant and concerning predictions stemming from this research is the dramatic decline in Earth’s atmospheric oxygen levels. Our planet’s current oxygen-rich atmosphere is a unique feature, a “biosignature” often sought by astronomers searching for life on other worlds. However, this study reveals that this life-sustaining oxygen is a temporary phenomenon, destined to disappear.
The models predict that atmospheric O₂ levels will eventually decrease in the distant future. In other words, anything that needs oxygen to survive will be gone in about a billion years. The study, published in Nature Geoscience, specifically found that the future lifespan of Earth’s oxygen-rich atmosphere, with oxygen levels over 1% of the current atmospheric level, is 1.08 ± 0.14 billion years. This deoxygenation is a critical, irreversible process.
This is a crucial detail because it shifts our understanding of the “end of life” timeline. It means the biosphere, with all its complex, oxygen-breathing organisms including humans and most plants, could collapse long before the planet becomes a scorching hot, waterless sphere. The research emphasizes that Earth’s atmosphere is currently rich in oxygen, but this won’t last forever, underlining the fragility of our planet’s life-support systems.

6. **A Scorched Earth: Rising Temperatures and Deteriorating Air Quality**As the Sun continues its evolutionary path, becoming hotter and brighter, its radiation will increasingly warm Earth’s surface. This rise in solar fluxes will have profound and devastating consequences, escalating global temperatures far beyond what life can endure. The study projects that Earth’s temperatures will rise exponentially, creating conditions that are fundamentally incompatible with the complex ecosystems we know today.
This warming will not only cause higher global temperatures but also have a devastating impact on air quality. Air will become increasingly polluted due directly to the increased heat, harming both plant and animal life further. The synergy of extreme temperatures and low-quality air will be among the principal indicators marking Earth’s slow, irreversible move away from being a livable environment, pushing it towards a state where only the hardiest, most basic forms of life might persist, if any.
One of the most critical long-term effects of this escalating heat is the eventual evaporation of Earth’s oceans. As surface temperatures continue to rise, water will no longer remain in liquid form, transforming our vast seas into vapor that will escape into space. Oceans are fundamental to regulating temperatures, providing oxygen, and supporting the majority of Earth’s biodiversity; without them, the entire planetary ecosystem will collapse, sealing the fate of any remaining life forms.

7. **The Collapse of the Carbon Cycle and Plant Life**Central to Earth’s ability to sustain life is the intricate global carbon cycle, which regulates atmospheric CO₂ levels and supports photosynthesis. However, the models predict that as the Sun ages and its energy output increases, these rising solar fluxes will fundamentally weaken this critical carbon cycle. This disruption will have a cascading effect, profoundly impacting plant life across the globe.
The weakening of the carbon cycle, combined with the escalating temperatures and diminishing water resources, will lead to the widespread death of plants. Plants are the primary producers of oxygen on Earth, essential for maintaining the current atmospheric composition through photosynthesis. Their demise will not only remove the base of most food webs but also directly halt the production of atmospheric oxygen, exacerbating the deoxygenation trend.
With plants unable to perform photosynthesis due to heat stress and CO₂ scarcity, the atmosphere will undergo a drastic transformation. This will be a key stage in the planet-wide decline in habitability, first making it difficult for complex organisms to survive, and eventually eliminating even microbial life. This chain of events vividly illustrates how interconnected Earth’s systems are, and how a change in one fundamental process can trigger irreversible planetary shifts.
Read more about: The 13 Pivotal Aspects of Silicon: Driving Innovation from Earth’s Crust to Digital Life

8. **Early Warning Signs: Solar Activity and Geomagnetic Storms**While the complete cessation of life on Earth is still billions of years away, the initial subtle shifts signaling our planet’s long-term decline are already becoming evident. Scientists are not merely theorizing about distant futures; they are observing real-time phenomena that offer tangible glimpses into the processes described by the supercomputer models. These early warning signs, particularly increased solar activity, serve as crucial indicators of the profound transformations awaiting Earth.
One of the most notable of these phenomena is the rising intensity of solar activity, including coronal mass ejections (CMEs) and solar storms. These powerful emissions from the Sun, where it ejects massive doses of energy and charged particles, have tangible impacts on Earth’s magnetic field and atmosphere. Such events, while natural, are now occurring with greater frequency, offering scientists a unique opportunity to study the subtle, long-term effects described in their predictive models.
Indeed, a significant event occurred recently, with “the most powerful solar storm in 20 years” being recorded. Such “G5” level geomagnetic storms can heat Earth’s upper atmospheric layer, the thermosphere, to abnormally high temperatures and even disrupt our communication networks and electrical grids, as was the case during the Carrington Event of 1859. These increased solar activities are not just theoretical projections; they are real-time evidence of the long-term transformations that could make Earth inhospitable, subtly reducing atmospheric oxygen and disturbing our planet’s delicate balance.

9. **The Double Whammy: Human-Driven Climate Change Accelerates Decline**Adding a critical layer of complexity to the Sun’s inevitable geological changes is the accelerating impact of human-driven climate change. The supercomputer models predict a slow, natural decline over eons, but human actions are compounding planetary stress, potentially accelerating environmental challenges far earlier than the billion-year benchmark. This creates a “double whammy” effect, where natural and anthropogenic forces conspire to push Earth towards uninhabitability at an even faster pace.
Human activities, most notably the combustion of fossil fuels and extensive deforestation, have already introduced significant alterations to our planet’s environment. We are witnessing record-high global temperatures, rapidly melting polar ice caps, and increasingly turbulent ecosystems. These changes are not just immediate concerns; they represent a significant exacerbation of the natural processes that will eventually lead to Earth’s demise, reducing its capacity to preserve life at significantly quicker rates than originally envisioned.
As Kazumi Ozaki, the study’s lead author, noted, previous estimates suggested Earth’s biosphere would end in two billion years. However, newer models “pretty much cut that period in half,” predicting rapid deoxygenation and an increasingly hostile environment within approximately one billion years. The combined weight of solar evolution and human-induced climate change is tipping the already unavoidable impacts of the Sun’s future heat emanation, presenting a stark reminder of our species’ profound, albeit often unintentional, influence on our planet’s long-term fate.

10. **Technological Interventions: Crafting Earth-Bound Sanctuaries**Despite the distant timeline, researchers emphasize the crucial importance of preparation and adaptation. Recognizing the inevitability of Earth’s eventual decline, scientists are actively exploring proactive strategies, including advanced technological interventions designed to prolong habitability for as long as possible. These visionary solutions aim to create pockets of survivability, shielding life from the encroaching environmental degradation.
One of the most compelling proposals involves the construction of enclosed life-support systems and artificial habitats. These sophisticated systems would function as controlled, self-sustaining environments, meticulously engineered to protect organisms from the decaying conditions of the broader Earth. Such habitats could potentially allow humans and other crucial species to continue thriving in isolated, closed ecosystems, effectively creating a series of Earth-bound sanctuaries.
Building and maintaining these advanced technological solutions would require immense ingenuity and global cooperation. These efforts would represent a palliative measure, an active response to the global environmental transformations that will unfold over geological timescales. While not a permanent solution, these interventions could significantly extend the window for life on Earth, offering a chance for adaptation and further scientific advancement in the face of an increasingly hostile world.

11. **The Ultimate Escape: The Drive for Space Colonization**When confronting the ultimate uninhabitability of Earth, humanity’s gaze naturally turns skyward, envisioning a future beyond our home planet. Long-term space colonization is emerging as a leading, albeit ambitious, strategy for preserving human life once Earth becomes genuinely inhospitable. This grand endeavor represents humanity’s ultimate bid for survival, transcending planetary boundaries to secure a future among the stars.
Organizations like NASA, in collaboration with private industry partners such as SpaceX, are at the forefront of developing the necessary technologies and methods for space exploration and colonization. Their missions to Mars and beyond are not merely scientific expeditions; they are foundational steps towards creating human settlements on other celestial bodies. These efforts aim to guarantee humanity’s survival long after Earth’s ability to support life has ceased.
The pursuit of space colonization is driven by a profound understanding that nothing, not even our resilient Earth, lasts forever. By establishing new homes in the cosmos, humanity could ensure its continued existence, carrying the torch of life across the solar system and perhaps even beyond. It is a testament to our species’ enduring spirit of innovation and adaptation, a monumental undertaking that promises to redefine our place in the universe.

12. **Rethinking Astrobiology: New Paradigms for Detecting Life Beyond Earth**The groundbreaking predictions regarding Earth’s future habitability carry profound implications, not just for our planet, but for the entire field of astrobiology. The study challenges long-held assumptions about how we identify and search for life on other planets, prompting a significant re-evaluation of our methodologies and priorities in the quest for extraterrestrial life. This research compels us to adopt new paradigms, acknowledging the dynamic nature of planetary biosignatures.
For decades, astronomers have predominantly focused on the presence of atmospheric oxygen as a primary biosignature when searching for life on exoplanets. Our own oxygen-rich atmosphere is a powerful indicator of complex life, a direct result of billions of years of photosynthetic activity. However, this new research vividly demonstrates that “Earth’s atmosphere is currently rich in oxygen, but this won’t last forever.” The study highlights that oxygen is a temporary feature, not a permanent one, even on living planets.
This crucial insight means that if we exclusively seek oxygen-rich atmospheres, “we might be overlooking planets that had life in the past or will have life in the future” but currently lack abundant O₂. It underscores the need for discovering strong biosignatures for exoplanets, especially those with little or no oxygen, encouraging a broader perspective that accounts for the evolutionary stages of planetary habitability. Understanding Earth’s own long-term atmospheric evolution becomes a vital lens through which to interpret potential signs of life elsewhere.

13. **Beyond the Billion-Year Horizon: Implications for Present-Day Actions**While the projected timeline for Earth’s ultimate uninhabitability extends far into the future, the findings of this supercomputer simulation are not merely academic exercises in distant prognostication. They hold significant implications for our present-day actions and offer a unique, long-range perspective on planetary stewardship. This understanding compels us to consider how our choices today resonate across geological timescales, shaping the conditions for future generations.
The research unequivocally underscores the delicate balance that sustains life on our planet. Our current climate system, atmosphere, and ecosystems are not eternal; they are dynamic and evolving. This perspective should fuel a renewed commitment to addressing the immediate challenges of human-driven climate change, which, as the study highlights, is already compounding planetary stress and accelerating environmental degradation. Developing sustainability policies that ensure Earth’s habitability for as long as possible becomes an ethical imperative.
Furthermore, this glimpse into Earth’s far future emphasizes the importance of investing in climate science and enhancing space exploration. These twin endeavors, while seemingly disparate, are inextricably linked. A deeper understanding of our own planet’s long-term changes informs our search for habitable worlds, while the pursuit of off-world settlements offers a potential safety net. The research, therefore, acts as a powerful reminder that “nothing lasts forever, not even Earth’s ability to support life,” urging us to act thoughtfully and decisively in the present.

14. **An Evolving Cosmos: Earth’s Place in the Grand Narrative of Stellar Evolution**The supercomputer predictions by NASA and Toho University, while providing a stark timeline for Earth’s end, ultimately offer a profound cosmic perspective. Our planet’s journey from a vibrant blue orb to a scorched wasteland is not a unique tragedy but a testament to the grand, inexorable forces of stellar evolution that govern the lives and deaths of stars and their orbiting worlds. It reminds us that Earth is but one player in an evolving cosmos, subject to the same cosmic laws as countless other planetary systems.
Life on Earth has demonstrated remarkable resilience, enduring asteroid impacts, multiple ice ages, and supervolcanic eruptions throughout its billions of years. However, even the toughest life forms will eventually face extinction, not because of human action, but because of the natural life cycle of our central star. The Sun’s transition from a stable G-type main-sequence star to a red giant is a predictable astronomical event, a process that will ultimately render our planet inhospitable, long before it physically engulfs it.
Thanks to these cutting-edge models and simulations, we now possess an extraordinary glimpse into the far future of Earth, providing a clearer picture of how and when that end might come. It’s not a prediction designed to instill fear, but rather to foster a deeper scientific understanding—for the sake of future generations and to contextualize our cherished place in the vast, dynamic, and ever-changing universe. This scientific endeavor elevates our comprehension of planetary environments, affirming that even celestial bodies, like all things, have a lifespan.
This journey through Earth’s distant future, guided by the precision of supercomputer simulations, provides a sobering yet profoundly insightful narrative. It illustrates that while humanity grapples with immediate environmental challenges, the ultimate fate of our world is woven into the fabric of stellar evolution, a cosmic clock ticking towards an inevitable end. Yet, this understanding is not a surrender to destiny, but a powerful call to action – to cherish our unique planetary home, to tirelessly pursue scientific knowledge, and to thoughtfully plan for a future that, through ingenuity and exploration, might just extend the extraordinary story of life beyond Earth’s final breath.